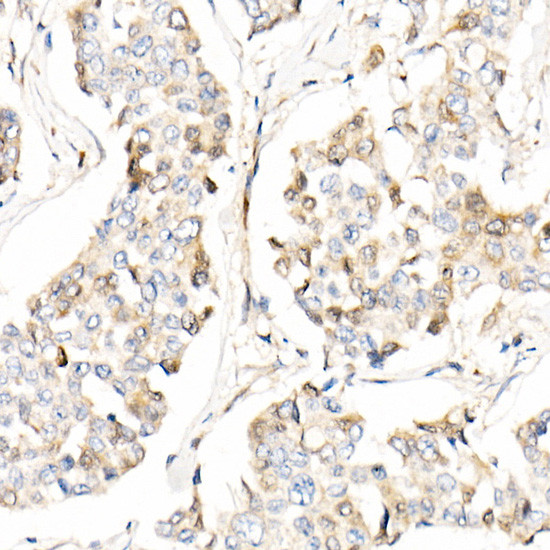
AMID Antibody in Immunohistochemistry (Paraffin) (IHC (P))

Search
Invitrogen
AMID Polyclonal Antibody
{{$productOrderCtrl.translations['antibody.pdp.commerceCard.promotion.promotions']}}
{{$productOrderCtrl.translations['antibody.pdp.commerceCard.promotion.viewpromo']}}
{{$productOrderCtrl.translations['antibody.pdp.commerceCard.promotion.promocode']}}: {{promo.promoCode}} {{promo.promoTitle}} {{promo.promoDescription}}. {{$productOrderCtrl.translations['antibody.pdp.commerceCard.promotion.learnmore']}}
图: 1 / 4
AMID Antibody (PA5-88365) in IHC (P)




Please note: We are reviewing Western blot images included in the antibody testing data in our catalog, including those provided by third parties. Unless expressly labeled or annotated as “raw-unedited”, Western blot images included in the antibody testing data in our catalog may have been edited, optimized or otherwise adjusted for presentation.
产品信息
PA5-88365
种属反应
已发表种属
宿主/亚型
分类
类型
抗原
偶联物
形式
浓度
规格
纯化类型
保存液
内含物
保存条件
运输条件
RRID
产品详细信息
Immunogen sequence: KDSFHHNVAA LRASVETGFA KKTFISYSVT FKDNFRQGLV VGIDLKNQMV LLQGGEALPF SHLILATGST GPFPGKFNEV SSQQAAIQAY EDMVRQVQRS RFIVVVGGGS AGVEMAAEIK TEYPEKEVTL IHSQVALADK ELLPSVRQEV KEILLRKGVQ LLLSERVSNL EELPLNEYRE YIKVQTDKGT EVATNLVILC TGIKINSSAY RKAFESRLAS SGALRVNEHL QVEGHSNVYA IGDCADVRTP KMAYLAGLHA NIAVANIVNS VKQRPLQAYK PGALTFLLSM GRNDGVGQIS GFYVGRLMVR LTKSRDLFVS TSWKTMRQS
Positive Samples: HepG2, A-549; Cellular Location: Cytoplasm, Lipid-anchor, Membrane, Mitochondrion outer membrane
靶标信息
The p53 tumor suppressor protein induces cell cycle arrest or apoptosis in response to cellular stresses. PRG3 (p53-responsive gene 3), is induced specifically under p53-dependent apoptotic conditions in human colon cancer cells. PRG3 has significant homology to bacterial oxidoreductases and the apoptosis-inducing factor, AIF. Unlike AIF, PRG3 localizes in the cytoplasm and its ectopic expression induces apoptosis. The PRG3 gene is thus a novel p53 target gene in a p53-dependent apoptosis pathway.
仅用于科研。不用于诊断过程。未经明确授权不得转售。
生物信息学
蛋白别名: AMID; apoptosis-inducing factor (AIF)-like mitochondrion-associated inducer of death; apoptosis-inducing factor 2; Apoptosis-inducing factor homologous mitochondrion-associated inducer of death; apoptosis-inducing factor-like mitchondrion-associated inducer of death; apoptosis-inducing factor-like mitochondrion-associated inducer of death; Ferroptosis suppressor protein 1; FSP1; MBP2; MBPH; MGC126662; MGC141971; p53-responsive gene 3 protein; RP11-367H5.2
基因别名: 5430437E11Rik; Aifm2; Amid; D730001I10Rik; PRG3
UniProt ID: (Mouse) Q8BUE4
Entrez Gene ID: (Mouse) 71361, (Rat) 361843